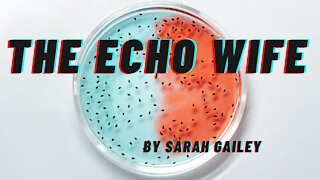
THE ECHO WIFE by Sarah Gailey

Premium Only Content
This video is only available to Rumble Premium subscribers. Subscribe to
enjoy exclusive content and ad-free viewing.

THE WIFE BETWEEN US by Greer Hendricks and Sarah Pekkanen
4 years ago
5
Doesn't the title say it all ? NO - IT DOESN'T !
Loading comments...
-
4:24
4:24
BOOKS, BOOKS, BOOKS
4 years agoTHE ECHO WIFE by Sarah Gailey
18 -
 LIVE
LIVE
OhHiMark1776
5 days ago🟢12-06-25 ||||| HMR. 21: King of the Hill ||||| Halo MCC (2019)
64 watching -
 20:08
20:08
MYLUNCHBREAK CHANNEL PAGE
8 hours agoThe Field Museum is From Another Timeline
54.7K10 -
 LIVE
LIVE
BigTallRedneck
54 minutes agoRUMBLE SPARTANS HALO NIGHT
80 watching -
 LIVE
LIVE
AirCondaTv Gaming
1 hour agoHalo: The Master Chief Collection - Conda a Clause is Spreading some Plasma Holiday Cheer (Collab)
50 watching -
 3:22:01
3:22:01
SpartakusLIVE
4 hours agoSOLOS on ARC Raiders || WZ Stream LATER
126K1 -
 LIVE
LIVE
GritsGG
6 hours agoBO7 Warzone Is Here! Win Streaking! New Leaderboard?
226 watching -
 1:00:55
1:00:55
Jeff Ahern
5 hours ago $8.75 earnedThe Saturday show with Jeff Ahern
54.3K16 -
 LIVE
LIVE
Ouhel
8 hours agoSATURDAY | Battlefield 6 | Going for the Queen in Arc after | O'HELL LIVE |
56 watching -
 LIVE
LIVE
ShivEmUp
6 hours ago🔴LIVE🔴🔵Battlefield 6🔵Game Changing Updates?🔵Grumpy Bird🔵
35 watching